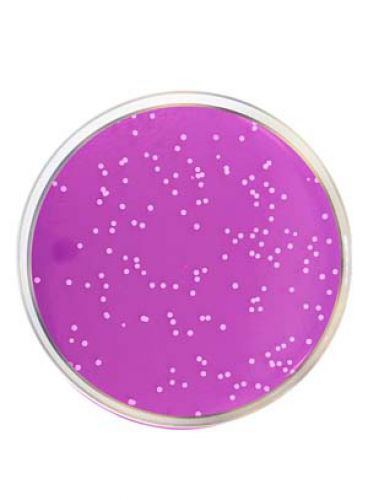
|محیط کشت رز بنگال آگار مرک بسته 500 گرمی
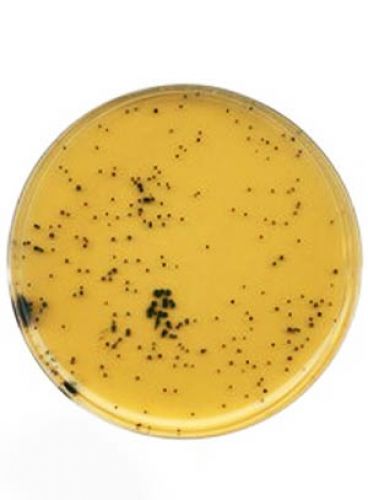
|محیط کشت تریپتوز سولفید سیکلوسرین برند مرک بسته 500 گرمی

محیط کشت عصاره قلب و مغز براث برند مرک بسته 500 گرمی
You4537محیط کشت bhi آگار یک محیط رشد غنی برای رشد و جداسازی میکروارگانیسم های سخت رشد است. از این محیط کشت جهت رشد باکتری های هوازی، بی هوازی، مخمر و ... استفاده می شود. این محیط کشت از ترکیب عصاره قلب و مغز گاو و یا خوک در ترکیب با انواع مواد مغذی ساخته شده است. محیط کشت اولیه bhi در سال 1919 توسط Rosenow معرفی شد، سپس با اضافه کردن بافت مغز گوساله به مایع دکستروز، محیط کشت مناسب برای رشد استرپتوکوک ها فراهم شد. در فرمولاسیون امروزی این محیط کشت، سدیم فسفات جایگزین کربنات کلسیم شده است. این محیط شامل پروتئین پپتون به عنوان منبع کربن، نیتروژن، اسید های آمینه، ویتامین های لازم، فسفات دی سدیم و کلرید سدیم است. هم اکنون در فروشگاه یونیت ؛ مشخصات و قیمت خرید محیط کشت عصاره قلب و مغز براث برند مرک بسته 500 گرمی را ملاحظه می کنید. در ادامه می توانید ویژگی های دقیق این محصول را بررسی کنید.
این محصول شامل ۱۰٪ ارزش افزوده می شود
گروه : محیط کشت
برند : MERCK
زمان تحویل : ۳ الی ۵ روز